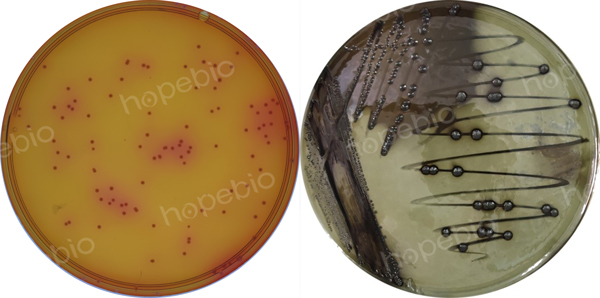

海博微信公众号
海博微信公众号
 海博天猫旗舰店
海博天猫旗舰店


 海博微信公众号
海博微信公众号
 海博天猫旗舰店
海博天猫旗舰店




引言
微生物监测是评估近岸河流水环境质量的重要环节,污水中常含有一定数量的病原微生物,是引发水传播疾病的重要来源。其中较为常见且具有重要影响的包括:沙门氏菌属、志贺氏菌属、肠道病原性大肠埃希氏菌以及肠道病毒等。沙门氏菌是由人、畜患者或带菌者随粪便排出的致病菌。本文以《水和废水监测分析方法(第四版)》为参考依据,选取具有代表性的沙门氏菌属,系统阐述其测定方法与流程,旨在为实际监测工作提供参考。
对于样品采集及采样点位设置的相关内容可参考《近岸河流水域微生物取样方法及注意事项》及《近岸河流水域微生物采样点位的布置方法及注意事项》。
一、测定流程图
水中沙门氏菌测定流程见下图。

二、水样的浓缩
1.浓缩的原因
由于污水中病原微生物的浓度往往较低,因此在检验时需对水样进行大规模浓缩,再开展培养、平板分离、生化试验及血清学检查等操作。鉴于沙门氏菌在水中的存在形式具有较大变异性(目前已知沙门氏菌属有1700种以上血清型),且分离技术在灵敏度和选择性方面存在局限性,因此任何检测方法得到的阴性结果,均不能表明水中完全不存在沙门氏菌属菌种,也不代表其他病原微生物不存在。
2.水样浓缩
水样采集量需依据水中沙门氏菌的浓度确定:通常饮用水为5000mL,饮用水源水为1000mL,污水为1mL~100mL。若水样量在100mL以下,可直接进行检验,无需浓缩;若超过100mL,则需采用滤膜法浓缩。
当水样浊度较低时,可通过孔径0.45μm、盘面直径142mm的无菌滤膜过滤收集微生物;若水样较为混浊,需先在滤膜表面敷盖硅藻土,具体操作如下:制备1L浓度为5g/L的硅藻土悬浮液(以蒸馏水配制),过滤500mL后,在悬浮液过滤接近完成时,迅速将水样注入剩余悬浮液中继续过滤,过滤结束后取出滤膜。
三、沙门氏菌的定性检验
1.前增菌
将滤膜无菌条件下转移至含有100mL缓冲蛋白胨水的容器中。若样品量为10mL~100mL,需加入等体积的双倍浓度缓冲蛋白胨水;若样品量为1mL~10mL,则加入10倍体积的普通浓度缓冲蛋白胨水,于37℃培养16h~20h。
2.增菌
将前增菌样品按1:10的比例转接至增菌液中(即10mL前增菌样品加入100mL增菌液)。需注意:当非沙门氏菌的密度较高时,建议按1:100的比例转接。
接种后的增菌液培养条件如下:
四硫磺酸盐培养液(TTB):43℃培养22h和44h;
氯化镁-孔雀绿培养液(RVS):37℃培养22h;
双倍浓度亚硒酸盐SF培养液:37℃培养24h。
注意:若水样中沙门氏菌密度较低或菌体在环境中受到损伤(如经消毒剂处理),建议采用前增菌-四硫磺酸盐增菌液组合;若沙门氏菌密度较高,可使用氯化镁-孔雀绿增菌液;若需检验水中伤寒沙门氏菌,则应采用前增菌-双倍浓度亚硒酸盐F增菌液组合。
3.选择性培养基
增菌培养后,将培养物接种至酚红煌绿琼脂和亚硫酸铋琼脂培养基表面。酚红煌绿平板于37℃培养24h,亚硫酸铋平板于37℃培养24h和48h,随后观察典型沙门氏菌落的存在情况。其中,酚红煌绿平板上的沙门氏菌菌落呈粉红色,亚硫酸铋平板上的菌落为灰黑色并带有金属光泽,菌落下方的培养基呈黑色。
沙门氏菌在酚红煌绿平板和亚硫酸铋平板上的生长特征
4.纯化及生化反应
从每种选择性平板的每个平皿中选择2~3个典型或可疑菌落接种至营养琼脂37℃下培养22h进行纯化。使用纯化后的菌落进行证实试验。
① 三糖铁试验:使用接种针在培养基表面划线,然后进行底部穿刺。37℃下培养18h~22h,培养基的变化解释如下:
|
底部 |
黄色(产酸) |
葡萄糖转变 |
|
红色或不变色(碱性或中性不变) |
葡萄糖不转变 |
|
|
黑色 |
硫化氢形成 |
|
|
气泡或裂缝 |
产气 |
|
|
斜面 |
黄色(产酸) |
乳糖和(或)蔗糖转变 |
|
红色或不变色 |
乳糖和蔗糖均不转变 |
典型反应(在斜面/底层中K,A和N分别代表碱性,酸性和中性反应;G代表产气,H2S 1+至4+代表由于H2S引起的变黑程度)。
沙门氏菌:斜面呈碱性(K)/底层呈酸性(A)并产气(G),硫化氢生成量为1+至4+;
伤寒沙门氏菌:斜面呈碱性(K)/底层呈酸性(A),硫化氢生成量微弱至1+。
② 脲酶试验:在琼脂斜面表面划线,37℃培养1d~2d。若反应呈红色,表明脲酶阳性;若呈黄色,表明脲酶阴性。沙门氏菌为脲酶试验阴性。
③ 苯丙氨酸脱氨试验:在琼脂斜面表面重新接种,37℃培养18h~24h后,向生长的斜面上滴加4~5滴10%氯化镁溶液。若琼脂表面和液体呈墨绿色,为阳性反应;若呈黄色或棕色,为阴性反应。沙门氏菌为苯丙氨酸脱氨阴性。
④ 吲哚试验:将可疑菌落接种到含5 mL培养液的试管内,37℃培养24h,加入1mL 吲哚试剂,若形成红色圆环,为阳性反应;若形成黄褐色圆环,为阴性反应。沙门氏菌为阴性反应。
⑤ 赖氨酸脱羧试验:接种于液体培养基表面以下,37℃培养24h。细菌生长后若呈紫色,表示阳性反应;若呈黄色,表明阴性反应。沙门氏菌为赖氨酸脱羧酶阳性。
⑥ β-半乳糖苷酶试验:在含有0.25mL生理盐水的小试管中,挑取可疑菌落制成菌悬液,滴加一滴甲苯,摇匀后置于37℃水浴中数分钟,再加入0.25mL的β-半乳糖苷酶试剂并混合,再将试管置于37℃水浴中24h。若呈黄色,表明阳性反应。大多数沙门氏菌为阴性,通常可在20min后观察结果。
5.血清学证实试验
使用三糖铁琼脂斜面上的纯菌落。去除自身凝集菌株,用多价抗O血清、多价抗H血清和抗Vi血清进行测定。如有凝聚作用,反应为阳性。
6.证实试验的结果分析
① 具有典型生化反应或血清学反应的菌株为沙门氏细菌。
② 具有典型生化反应,而多价抗O血清、多价抗H血清或抗Vi血清不为阳性的菌株;或不具有典型生化反应,而具有典型血清学反应的菌株;或具有典型生化反应的自身凝集的菌株可能是沙门氏菌。
③ 不具有典型生化反应和血清学反应的菌株为非沙门氏细菌。
④ 被认为是沙门氏菌的菌株或可疑的菌株,应进一步检验其类型。
|
试验项目 |
反应 |
现象 |
|
三糖铁 |
|
|
|
葡萄糖(产酸) |
+ |
琼脂下部变黄 |
|
葡萄糖(产气) |
+* |
琼脂下部有气泡或开裂 |
|
乳糖 |
-** |
琼脂斜面为红色(不变化) |
|
果糖 |
- |
琼脂斜面为红色(不变化) |
|
硫化氢 |
+* |
琼脂下部变黑 |
|
脲酶 |
- |
黄色(不变化) |
|
苯丙氨酸 |
- |
加试剂为褐黄色 |
|
吲哚 |
- |
加试剂为黄色 |
|
赖氨酸脱羧酶 |
+ |
紫色 |
|
β-半乳糖苷酶 |
-** |
不变色 |
*伤寒沙门氏菌不产气,不形成H2S。
**沙门氏菌Ⅲ亚属(亚利桑那菌)乳糖和β-半乳糖苷酶试验为阳性,Ⅱ亚属乳糖为阴性而β-半乳糖苷酶试验为阳性。
7.报告结果
根据实验结果,报告一定体积的检验水样中存在或不存在沙门氏细菌。
四、沙门氏菌的定量检验
水样中沙门氏菌的密度也可用MPN法进行估计。样品量为:
|
水样种类 |
样品量 |
|
饮用水 |
5×1000mL |
|
饮用水源水 |
5×100mL |
|
其他天然水 |
5×10mL |
|
5×1mL |
|
|
废水 |
5×1mL |
|
5×0.1mL |
|
|
5×0.01mL |
|
|
污水 |
5×0.1mL |
|
5×0.01mL |
|
|
5×0.001mL |
使用的培养基和操作步骤同定性检验。根据出现的阳性管和阴性管数,查MPN表,然后计算每升水样中的沙门氏菌数。
五、相关培养基的采购
开云手机登录中心有适用于水中沙门氏菌检验的相关培养基,客户可根据实际情况和用途进行选用。
|
产品编号 |
产品名称 |
规格 |
产品说明及用途 |
|
HB4084 |
250g |
用于沙门氏菌前增菌培养, 亦可用于李斯特氏菌前增菌培养 (GB、SN标准) |
|
|
HB4086-10 |
250g |
用于沙门氏菌选择性增菌培养 |
|
|
HB4198-25 |
250g |
用于沙门氏菌的选择性增菌培养 |
|
|
HB8396 |
250g |
用于饲料中沙门氏菌分离培养 |
|
|
HB4090-6 |
250g |
用于沙门氏菌选择性分离培养 |
|
|
HB0109 |
250g |
用于一般细菌培养、转种、复壮和增菌等 |
|
|
HB4088-13 |
250g |
用于肠杆菌科细菌的生化反应筛选 |
注:本文属海博生物原创,未经允许不得转载。
上一篇:培养基中的难溶成分及其溶解技巧
下一篇:钠盐在培养基中的作用及差异
| 相关文章: | ||



